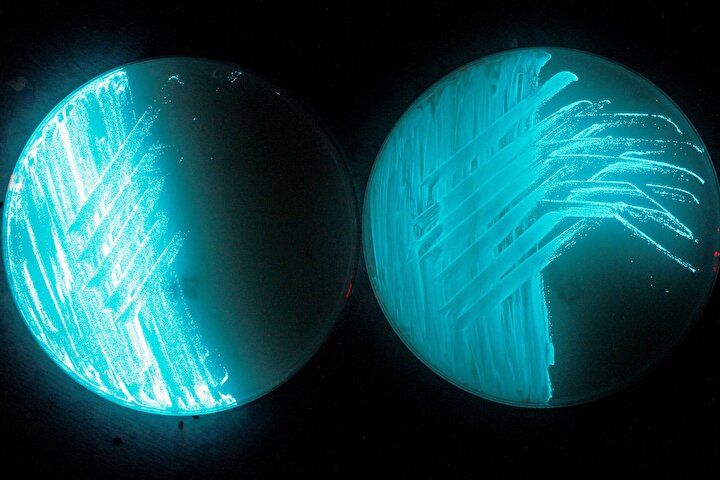

Bakteriler tarafından aydınlatılacak Fransız kasabası
11 Nisan 2022, Pazartesi
Toplam 6 sayfadan 2. sayfadasınız. Rambouillet'teki projenin arkasındaki Fransız start-up Glowee'nin kurucusu Sandra Rey, "Amacımız şehirlerin ışığı kullanma şeklini değiştirmek" dedi. Vatandaşlara, çevreye ve biyolojik çeşitliliğe daha fazla saygı duyan bir ortam yaratmak ve bu yeni ışık felsefesini gerçek bir alternatif olarak empoze etmek istiyoruz." diyerek sözlerine devam etti.
Rambouillet'teki projenin arkasındaki Fransız start-up Glowee'nin kurucusu Sandra Rey, "Amacımız şehirlerin ışığı kullanma şeklini değiştirmek" dedi. Vatandaşlara, çevreye ve biyolojik çeşitliliğe daha fazla saygı duyan bir ortam yaratmak ve bu yeni ışık felsefesini gerçek bir alternatif olarak empoze etmek istiyoruz." diyerek sözlerine devam etti.
Rambouillet'teki projenin arkasındaki Fransız start-up Glowee'nin kurucusu Sandra Rey, "Amacımız şehirlerin ışığı kullanma şeklini değiştirmek" dedi. Vatandaşlara, çevreye ve biyolojik çeşitliliğe daha fazla saygı duyan bir ortam yaratmak ve bu yeni ışık felsefesini gerçek bir alternatif olarak empoze etmek istiyoruz." diyerek sözlerine devam etti.
Rambouillet'teki projenin arkasındaki Fransız start-up Glowee'nin kurucusu Sandra Rey, "Amacımız şehirlerin ışığı kullanma şeklini değiştirmek" dedi. Vatandaşlara, çevreye ve biyolojik çeşitliliğe daha fazla saygı duyan bir ortam yaratmak ve bu yeni ışık felsefesini gerçek bir alternatif olarak empoze etmek istiyoruz." diyerek sözlerine devam etti.











